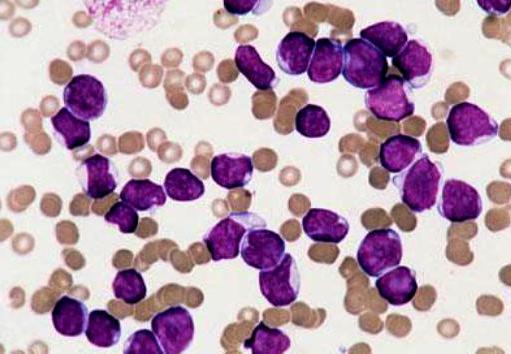

Заражение лейкозом
Поздравление с рождением мальчика 20 лет
Полировка лака по дереву
Как не помять футболки в чемодане
Сколько от воронежа до абхазии
Типы сказуемых в предложениях примеры
Метафора в стихотворении зимнее утро
Уколы в подмышки от пота отзывы
Майкоп газовое оборудование
Как открыть счет в казахстане 2025
План счетов государственных учреждений рк
Цитрусовые смеси
Клопы фото квартирные крупным планом
Датчик распредвала ларгус 16 клапанов
Заражение лейкозом 112 фото